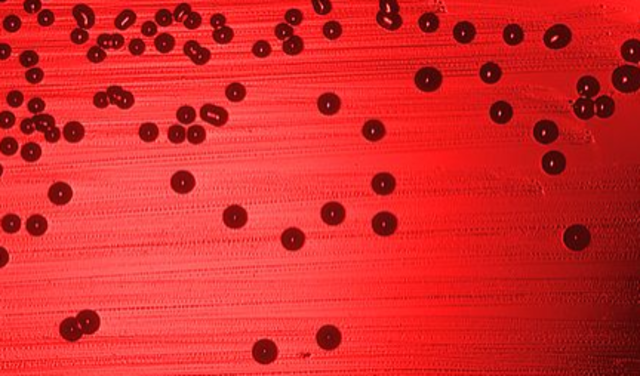
First complete genome

-
The thermometer measures a temperature gradient. It wasn't until 1625 when an Italian physician modified the thermometer and used it as a medical thermometer.
-
Janssen was credited with creating the first compound microscope. This is an important discovery as we use microscopes day in and day out. 5 years later a single lens microscope emerged.
-
Anton Leeuwenhoek develops the first microscope.
-
Galileo Galilei, a physicist builds a telescope after hearing of its invention a year earlier in 1608. Biologists created the first microscope 9 years earlier. The time discrepancy of these inventions may be due in part to funding but are important tools nonetheless.
-
Robert Hooke sees cells in a cork using a microscope.
-
Issac Newton designs and builds a reflecting telescope, nearly 60 years after the first telescope was constructed.
-
Anton Leewenhoek describes microscopic life -something that had not been done yet. He sent letters to the British Royal Society describing his observations.
-
Anton Von Leeuwenhoek identifies blood cells. No further blood cells were discovered until 1842 when a french physician discovered platelets a year after that leukocytes were first observed. Through these discoveries the field of hematology emerged. It was not until 1879 when a technique for staining blood films and differential blood cell counting was discovered.
-
Jan Ingenhousz reported that plants produced oxygen. It wasn't until 1845 that Nicolas-Theodore Saussure was able to draw all the pieces of photosynthesis together.
-
Carolus Linnaeus begins the modern description of life.
-
Benjamin Franklin conducts experiments that show that one type of electrification could be neutralized by other types. indicating that the two types of electricity were not merely different, but opposites, one being positive and the other being negative.
-
Alessandro Volta invents the battery
-
John Dalton develops his atomic theory, although in 425 BC Democritus proposed that all matter is made of small indivisible particles that he called "atoms" It took thousands of years for this theory to take off. This is the smallest un-seeable particle known. Biologists first saw cells in 1663, a century before the development of the atomic theory.
-
Jean Baptiste Lamarack proposes a modern theory of evolution based on the inheritance of acquired characteristics. Darwin does not propose his evolution by means of natural selection until 1859, nearly 50 years later.
-
Andre Ampere shows that two wires carrying electric currents attract each other. Nearly 75 years after Franklin showed that there were positive and negative electricity.
-
Karl von Baer shows that all animal life beings with an egg.
-
Georg Ohm showed that current and voltage are related by a very simple relationship known as ohm's law.
-
Micheal Faraday experimentally showed that a changing magnetic field produces an electric current. Faraday is considered to be one of the most influential scientists in history.
-
Matthias Schleiden proposes that all plants are composed of cells.
-
Theodor Schwann proposes that all animal tissues are composed of cells.
-
Robert Remak develops a method to isolate the cell membrane and proves it divides a cell. He conducted this by creating a chemical hardening agent which allowed him to observe how the membrane divided the cell.
-
Louis Pasteur states that microorganisms produce fermentation.
Fermentation is a metabolic process that converts sugars to acids, gases, or alcohol. -
Kolliker described mitochondria, what we now know as the 'powerhouse' of the cell.
-
Rudolf Virchow proposes that cells can ONLY arise from pre-existing cells. This was a hot topic among scientists and members of the church criticized this finding.
-
Charles Darwin proposes his theory of biological evolution by means of natural selection.
-
Louis Pasteur disproves the theory of spontaneous generation. This was a great leap forward for science since this theory ran counter to christian beliefs, this was a time when the church held lots of power and influence.
-
Gregor Mendel formulates his Laws of Inheritance. At this time in history biological laws of inheritance were highly controversial and scrutinized by religious believers.
-
Friefrich Miescher discovers nucleic acids in the nuclei of cells.
-
Dmitri Mendeleyev proposes his periodic table of chemical elements.
-
Johannes van der Walls develops his theory of intermolecular forces in fluids. This is an important discovery because it later gives us insight into intermolecular bonding in human bodies. This is applied in chemistry, physics, and biology.
-
Louis Pasteur proves germ theory of disease. Three of Pasteur's daughters died of infectious diseases. He did lots of scientific work on diseases confirming that they were caused by germs.
-
Edward Strasbourg coins the term cytoplasm to describe the cell's central fluid and establishes the cell's structure.
-
Walther Fleming coins the term mitosis to describe mitosis - nuclear division plus cytokinesis that produces two identical daughter cells. Meiosis is not discovered until 1905, 21 years later.
-
Wilhelm Roentgen discovers x-rays, his experiment involved passing of electric current through gases at extremely low pressures. Before this discovery broken bones, tumors, and location of bullets were all diagnosed by physical examination and a doc's best guess. This discovery was revolutionary in all aspects of science.
-
JJ Thompson determines the mass to charge ratio of the electron. The electron is a constituent for all the matter in our universe. All atoms are made of a nucleus and electrons. He received the Nobel Prize in 1906, nearly 9 years after his discovery.
-
Martinus Berijerinck uses filtering experiments to show that tobacco mosaic disease is caused by something smaller than a bacterium, which he names a virus.
-
Camillo Golgi discovers the Golgi apparatus. He invented a method of staining by hardening nervous cells in potassium bichromate and then impregnating a sample with silver nitrate. The Golgi apparatus is a complex of vesicles and folded membranes within the cytoplasm. The golgi was discovered 14 years after the cytoplasm.
-
Ernest Rutherford discovers alpha and beta radiation. Alpha radiation can trigger a fire alarm and beta radiation can be used to monitor the thickness of materials such as paper and plastic.
-
Walter Sutton and Theodor Boveri independently propose that the chromosomes carry the heredity information.
-
Scientists discover how specialized sex cells come about and describe meiosis.
-
Ernest Rutherford discovers the nucleus of the atom. Nearly a century after John Dalton proposes the atomic theory. Biologists first saw cells in 1663, a century before the development of the atomic theory and nearly two centuries before the discovery of the nucleus.
-
Thomas Hunt Morgan proposes that genes are arranged in a line on the chromosomes.
-
Banting and Best are credited with discovering the hormone insulin in the pancreatic extracts of dogs. They injected the hormone into a dog and found that it lowered high blood glucose levels to normal. A year later in 1992, insulin was used in the treatment of Diabetes in humans.
-
Alexander Fleming discovers penicillin, the first true antibiotic. It is still used today but many types of bacteria have developed resistance to it.
-
Karl Lohmann, a german chemist first discovered ATP and its structure was discovered a few years later. It wasn't until 1948 when ATP was chemically synthesized.
-
James Cadwick identifies the neutron and Heisenberg proposes that the nucleus of an atom is composed of proton and neutrons. These discoveries took longer than the discovery of the cell because atoms, neutrons, electrons are not directly visible under a scope or to the naked eye therefore taking longer to theorize and discover.
-
Tadeus Reichstein artificially synthesizes vitamin C -this is the first vitamin synthesis.
-
Niels Bohr publicly announces the discovery of fission, this announcement was the principal revelation of fission in the US. Three days later, Robert Oppenheimer realizes that during fission excess neutrons must be emitted and that it may be possible to build a BOMB...
-
Robert Oppenheimer was ready to test the first atomic bomb.
In Sept of 1939 Germany invaded Poland and began WW2, Oppenheimer was ready to test his bomb summer of 1945, a few months later in Aug the US dropped two atomic bombs on Japan. One has to wonder how WW2 would have ended had nuclear fission not been discovered yet. -
Hershey and Chase show that DNA is the genetic material in bacteriophage viruses expanding our knowledge of how viruses function.
-
Rosland Franklin concludes that DNA is a a double helix - Watson and Crick publish a double helix structure for DNA after examining Franklins work.
-
Arthur Kornberg discovers DNA polymerase enzymes
-
Grunberg-Manago and Ochoa discover the first nucleic acid synthesizing enzyme which links nucleotides together into polynucleotides
-
Robert Woodward synthesizes chlorophyll - the green pigments found in cyanobacteria and the chloroplasts of algae and plants.
-
Haemophilus influenzae, a commensal bacterium which resides in the human respiratory tract was the first organism to have its entire genome sequenced and published.
-
Dolly the sheep is the first clone of an adult mammal by the process of nuclear transfer. Dolly died from a progressive lung disease months before her 7th birthday.
-
Publications of the first drafts of the complete human genome. The human genome project is an international 13 year project that began in Oct 1990. It is important because it uses information from DNA to develop new ways to treat, cure and/or even prevent thousands of diseases that afflict the human race.
-
the first virus produced 'from scratch' an artificial polio virus that paralyzes and kills. This project was funded by the US Department of Defense as part of a biowarfare program, so it has attracted both criticism and praise. This marks the first time a genome has been synthesized without the help of a natural template. The polio virus attacks the central nervous system of humans and causes paralysis and ultimately death. It is highly contagious and can be transmitted through the air.
Looking for a timeline maker?
Create timelines for projects, roadmaps, history, lessons, legal cases, and stories with Timetoast. Timetoast is a timeline maker for work, school, research, and stories.